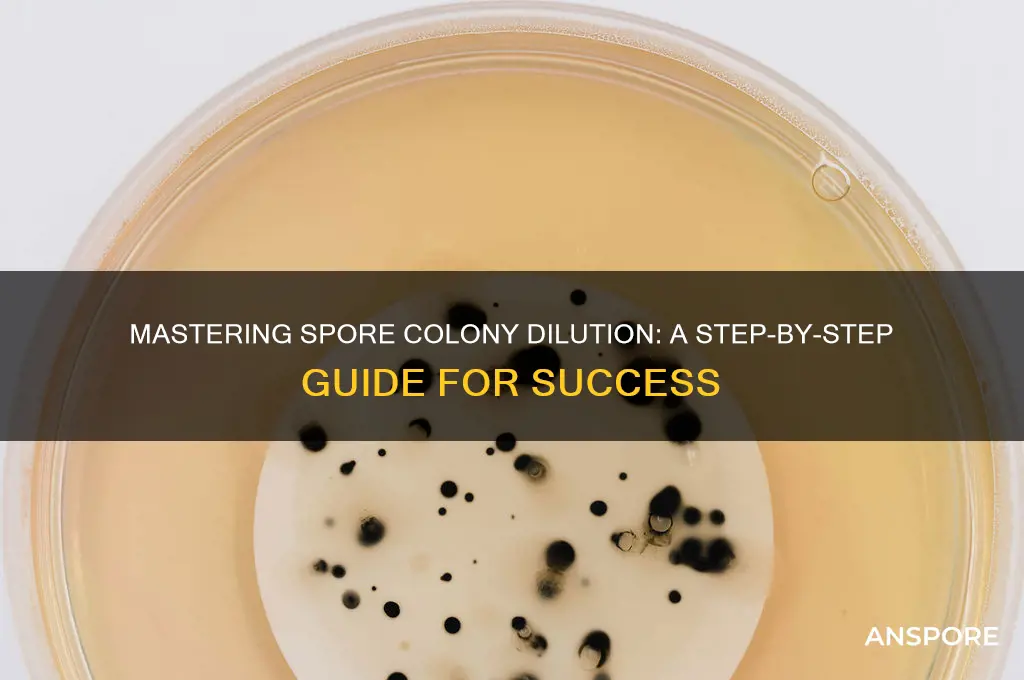
how to dilute spore colony

Diluting a spore colony is a critical technique in microbiology, essential for achieving accurate and reproducible results in experiments such as plating, enumeration, or inoculation. This process involves carefully reducing the concentration of spores in a suspension to a desired level, ensuring even distribution and preventing overcrowding on culture media. Proper dilution not only facilitates precise quantification of viable spores but also minimizes contamination risks and promotes consistent growth patterns. The method typically requires sterile techniques, precise measurements, and an understanding of the appropriate dilution factors to maintain the integrity of the sample. Whether using serial dilution or direct measurement, mastering this skill is fundamental for researchers and lab technicians working with microbial cultures.
| Characteristics | Values |
|---|---|
| Purpose | To reduce the concentration of spores in a sample for accurate counting, isolation, or further experimentation |
| Materials | Sterile diluent (e.g., distilled water, saline solution, or nutrient broth), sterile tubes, pipettes, vortex mixer or sonicating bath, and a sterile environment (e.g., laminar flow hood) |
| Dilution Factor | Typically 10-fold (1:10) or higher, depending on the initial spore concentration and desired final concentration |
| Dilution Series | Serial dilutions are often performed (e.g., 10-1, 10-2, 10^-3, etc.) to achieve a wide range of concentrations |
| Volume | Common dilution volumes range from 0.1 mL to 1 mL, depending on the sample size and desired final volume |
| Mixing Method | Vortex mixing or sonication is recommended to ensure thorough dispersion of spores in the diluent |
| Incubation Time | Not applicable for dilution itself, but subsequent steps (e.g., plating or germination) may require incubation |
| Sterility | Maintain sterility throughout the process to prevent contamination |
| Common Applications | Spore enumeration (e.g., plate counting), spore isolation, and spore germination studies |
| Precautions | Wear appropriate personal protective equipment (PPE), work in a sterile environment, and properly dispose of contaminated materials |
| Quality Control | Perform positive and negative controls to ensure accuracy and detect contamination |
| Storage | Store diluted spore suspensions at recommended temperatures (e.g., 4°C or -20°C) and use within a specified timeframe to maintain viability |
| References | Standard methods (e.g., ASTM, ISO) and laboratory-specific protocols should be consulted for detailed procedures and guidelines |
Explore related products
What You'll Learn
- Sterile Technique: Maintain cleanliness to prevent contamination during spore dilution process
- Spore Suspension: Gently mix spores in sterile solution for even distribution
- Dilution Series: Prepare sequential dilutions to achieve desired spore concentration
- Plating Methods: Spread diluted spores on agar plates for colony growth
- Incubation Conditions: Optimize temperature and time for accurate colony development

Sterile Technique: Maintain cleanliness to prevent contamination during spore dilution process
Contamination is the arch-nemesis of any spore dilution process, capable of rendering hours of work useless. Even a single stray microbe can outcompete your target spores, skewing results and wasting resources. This is where sterile technique becomes your most powerful weapon. It's not just about cleanliness; it's about creating a controlled environment where your spores can thrive without interference.
Every step, from preparing your workspace to handling your tools, demands meticulous attention to detail.
Imagine your workspace as a surgical theater. Begin by disinfecting all surfaces with a suitable disinfectant, like 70% ethanol or a 10% bleach solution. Allow sufficient drying time to prevent chemical residue from harming your spores. Autoclave all glassware and metal instruments at 121°C for 15-20 minutes to ensure complete sterilization. For heat-sensitive items, consider using sterile disposable alternatives. Don sterile gloves and a lab coat, minimizing exposed skin and clothing that could harbor contaminants. Remember, you're not just cleaning; you're creating a barrier against the microscopic invaders lurking everywhere.
Every movement, every breath, has the potential to introduce unwanted guests. Work in a laminar flow hood if available, providing a constant stream of sterile air to minimize airborne contamination.
The dilution process itself requires precision and vigilance. Flame the lip of your culture tubes or bottles with a bunsen burner before and after adding or removing anything to create a sterile zone. Use sterile pipettes and tips, changing them frequently to avoid cross-contamination. When transferring spores, employ aseptic technique: never lay down a pipette or open a container without first flaming the opening. Think of yourself as a surgeon, every movement deliberate and calculated to maintain the integrity of your sterile field.
Even the slightest lapse in concentration can have disastrous consequences.
Maintaining sterility extends beyond the dilution itself. Label all containers clearly and date them, ensuring proper identification and preventing accidental misuse. Store diluted spore suspensions at the appropriate temperature, typically 4°C for short-term storage or -20°C for long-term preservation. Regularly inspect your storage area for any signs of contamination, discarding any suspicious samples immediately. Remember, sterile technique is a mindset, a constant awareness of potential threats and a commitment to meticulous practice. By embracing this mindset, you'll ensure the success of your spore dilutions and the reliability of your results.
Exploring Spore's Age: A Journey Through Its Development Timeline
You may want to see also

Spore Suspension: Gently mix spores in sterile solution for even distribution
Spores, when suspended in a sterile solution, require careful handling to ensure even distribution and viability. This process, known as spore suspension, is critical in microbiology for applications like inoculation, storage, and experimentation. The key lies in gentle mixing to avoid damaging the spores while achieving homogeneity. Using a sterile solution, typically distilled water or a saline buffer, prevents contamination and maintains spore integrity. The technique demands precision: a vortex mixer or gentle pipetting can be employed, but excessive force must be avoided to preserve spore structure.
Consider the practical steps involved in creating a spore suspension. Begin by preparing a sterile solution, ensuring it is free from contaminants that could compromise the spores. Transfer a measured quantity of spores into the solution, using a sterile loop or pipette to maintain aseptic conditions. For optimal results, aim for a concentration of 10^6 to 10^8 spores per milliliter, depending on the intended use. Gently mix the suspension by inverting the tube 10–15 times or using a low-speed vortex for 5–10 seconds. Avoid shaking vigorously, as this can cause aggregation or damage.
The choice of sterile solution can significantly impact spore viability. Distilled water is commonly used for its simplicity, but a saline solution (0.85% NaCl) or phosphate-buffered saline (PBS) may better mimic physiological conditions, enhancing spore stability. For long-term storage, glycerol solutions (e.g., 20% glycerol in water) are preferred, as they protect spores from desiccation and freezing damage. Always verify the compatibility of the solution with the spore species, as some may have specific requirements.
A critical aspect of spore suspension is verifying even distribution. After mixing, allow the suspension to sit for 1–2 minutes to ensure any aggregates settle. If clumping persists, repeat the gentle mixing process. For precise applications, such as plating or inoculation, further dilution may be necessary. Serial dilutions (e.g., 1:10, 1:100) can be performed using the same sterile solution, ensuring each step maintains gentle handling. Always label dilutions clearly to avoid confusion during downstream experiments.
In conclusion, spore suspension is a delicate yet essential technique in microbiology. By gently mixing spores in a sterile solution, researchers can achieve even distribution while preserving spore viability. Attention to detail—from solution selection to mixing technique—ensures the suspension is suitable for its intended purpose. Whether for laboratory experiments or industrial applications, mastering this process is fundamental to working with spores effectively.
Can Mold Spores Get on Clothes? Understanding Risks and Prevention
You may want to see also

Dilution Series: Prepare sequential dilutions to achieve desired spore concentration
Dilution series are a cornerstone technique in microbiology, allowing researchers to achieve precise spore concentrations for experiments, quality control, or environmental analysis. This methodical approach involves systematically reducing the concentration of spores in a sample through a series of dilutions, each decreasing the spore count by a known factor. For instance, a 1:10 dilution reduces the concentration by a factor of ten, while a 1:100 dilution reduces it by a factor of one hundred. By carefully planning and executing these dilutions, scientists can isolate individual spores for plating, ensuring accurate colony counts and preventing overcrowding on agar plates.
To prepare a dilution series, begin with a well-mixed spore suspension. Using sterile technique, transfer 1 mL of the suspension into 9 mL of sterile diluent (e.g., saline or distilled water) in a labeled tube, creating a 1:10 dilution. Mix thoroughly by vortexing or gently inverting the tube. For further dilutions, transfer 1 mL from the 1:10 dilution into a new tube containing 9 mL of diluent, resulting in a 1:100 dilution. Repeat this process as needed, adjusting the dilution factor based on the desired final concentration. For example, a 1:1000 dilution would require an additional step, transferring 1 mL from the 1:100 dilution into 9 mL of diluent.
Precision is critical in this process. Use sterile, calibrated pipettes and ensure all tubes and diluents are free from contaminants. Label each tube clearly with the dilution factor to avoid confusion. For highly concentrated spore suspensions, consider starting with a higher initial dilution, such as 1:100, to avoid excessive spore clustering in early dilutions. Additionally, maintain a consistent volume ratio (e.g., 1:9) throughout the series to ensure mathematical accuracy in spore concentration calculations.
A practical example illustrates the utility of dilution series. Suppose you have a spore suspension with an estimated concentration of 10^8 spores/mL, but you need a concentration of 10^4 spores/mL for plating. Start with a 1:10,000 dilution (1 mL suspension in 99 mL diluent), followed by a 1:10 dilution of this solution (1 mL in 9 mL diluent), resulting in a final concentration of approximately 10^4 spores/mL. Plate 0.1 mL of this final dilution onto agar, and after incubation, count the colonies to verify the accuracy of the dilution series.
In conclusion, mastering the dilution series technique empowers microbiologists to manipulate spore concentrations with precision, a skill essential for reliable experimental results and practical applications. By understanding the principles of sequential dilutions and adhering to sterile techniques, researchers can achieve the exact spore counts needed for their work, whether in academic research, industrial quality control, or environmental monitoring.
Mold Spores and Bacterial Infections: Unraveling the Hidden Health Risks
You may want to see also
Explore related products

Plating Methods: Spread diluted spores on agar plates for colony growth
Diluting spore colonies and plating them on agar is a fundamental technique in microbiology, allowing researchers to isolate and cultivate individual colonies for further study. The process begins with a careful dilution of the spore suspension to ensure that when spread on the agar surface, the spores are adequately spaced, promoting the growth of distinct colonies. This method is crucial for various applications, from identifying microbial species to producing pure cultures for industrial use.
The Art of Dilution and Plating
To achieve optimal colony growth, start by preparing a series of decimal dilutions of the spore suspension. For instance, mix 1 mL of the spore solution with 9 mL of sterile saline or water to create a 10^-1 dilution. Repeat this process to achieve 10^-2, 10^-3, and higher dilutions, depending on the initial spore concentration. Use a sterile pipette to transfer 0.1 mL of the final dilution onto the center of a pre-warmed agar plate. Quickly but gently spread the liquid across the plate’s surface using a sterile L-shaped glass rod or a disposable spreader, ensuring even distribution without scratching the agar.
Practical Tips for Success
Allow the agar plate to dry for 10–15 minutes in a biosafety cabinet before inverting it for incubation. This step prevents condensation from dripping onto the colonies during growth. Incubate the plates at the appropriate temperature (e.g., 37°C for most bacteria) for 24–48 hours. For spore-forming organisms like *Bacillus*, consider a longer incubation period of 48–72 hours to ensure full colony development. Always label plates with the dilution factor, date, and organism name for traceability.
Troubleshooting Common Issues
If colonies are too crowded, increase the dilution factor (e.g., use 10^-5 or 10^-6 dilutions). Conversely, if no colonies appear, verify the viability of the spore suspension or check for contamination in the agar or diluent. Over-drying the agar plate can lead to poor colony growth, so ensure the surface remains moist during the spreading process. For heat-resistant spores, briefly heat the suspension (e.g., 80°C for 10 minutes) before dilution to activate germination and enhance plating efficiency.
Applications and Takeaways
Mastering this plating method is essential for microbial enumeration, antibiotic susceptibility testing, and genetic studies. It allows researchers to quantify colony-forming units (CFUs) per mL of the original sample, providing insights into microbial load and viability. By systematically diluting and spreading spores, scientists can isolate pure cultures for downstream experiments, ensuring reliable and reproducible results. This technique, though simple in principle, demands precision and attention to detail to yield accurate and meaningful data.
Preventing Spores: Effective Time and Temperature Control Strategies Explained
You may want to see also

Incubation Conditions: Optimize temperature and time for accurate colony development
Temperature and time are critical variables in the incubation of spore colonies, directly influencing their growth rate, morphology, and viability. Optimal conditions vary by species, but a general rule is to mimic the organism's natural environment. For example, *Bacillus subtilis* thrives at 37°C, while thermophilic fungi like *Chaetomium thermophilum* require temperatures between 50–60°C. Deviating from these ranges can result in stunted growth or false negatives. Always consult species-specific guidelines before setting incubation parameters.
To optimize incubation time, consider the spore's dormancy state and the desired colony size. Short incubation periods (e.g., 24–48 hours) may suffice for rapid growers like *Escherichia coli*, but slow-growing mycobacteria may require 2–4 weeks. Over-incubation risks confluent growth, making colony counting impossible, while under-incubation can lead to missed colonies. A practical tip: perform a preliminary time-course experiment to identify the window when colonies are distinct and countable.
Analyzing the interplay between temperature and time reveals a trade-off: higher temperatures accelerate growth but may compromise colony integrity, while lower temperatures preserve morphology but extend incubation time. For instance, incubating *Aspergillus* spp. at 25°C for 5–7 days yields well-defined colonies, whereas 37°C may cause rapid, fuzzy growth unsuitable for enumeration. Adjusting temperature by ±2°C can fine-tune results without sacrificing accuracy.
Instructive protocols often overlook humidity, yet it’s a silent influencer of spore germination and colony development. Maintain relative humidity at 90–95% during incubation to prevent desiccation, especially for fungal spores. Use saturated salt solutions (e.g., potassium chloride for 85% RH) or sealed incubation chambers to control moisture levels. Neglecting humidity can lead to inconsistent or failed germination, skewing dilution accuracy.
Finally, a comparative approach highlights the importance of consistency. Incubators with temperature fluctuations (±1°C) or uneven air distribution produce variable colony sizes, complicating dilution calculations. Invest in calibrated equipment and verify temperature uniformity with multiple sensors. For low-resource settings, DIY solutions like insulating incubators with foam or using water jackets can stabilize conditions. Precision in incubation conditions is non-negotiable for reliable spore dilution and colony counting.
Aspirating Fungal Spores from Adherent Cells: Techniques and Considerations
You may want to see also
Frequently asked questions
Diluting a spore colony helps achieve a manageable and countable number of spores for plating, ensuring accurate quantification and preventing overcrowding on agar plates.
You will need sterile water or a suitable diluent, a sterile tube, a pipette or sterile loop, and a vortex mixer or gentle shaking mechanism for thorough mixing.
First, resuspend the spore colony in sterile water using a sterile loop or pipette. Transfer the suspension to a sterile tube, add the appropriate volume of diluent, and mix thoroughly by vortexing or gentle shaking. Perform serial dilutions as needed.
Use sterile techniques, such as flame-sterilizing tools, working in a laminar flow hood, and using sterile diluents and containers, to prevent contamination during the dilution process.















![McKesson Cotton Tipped Applicator, 6 in [100 Count] Long Sterile Medical Swabs, Individually Wrapped, Wood Shaft](https://m.media-amazon.com/images/I/61y4nxRNd2L._AC_UY218_.jpg)















